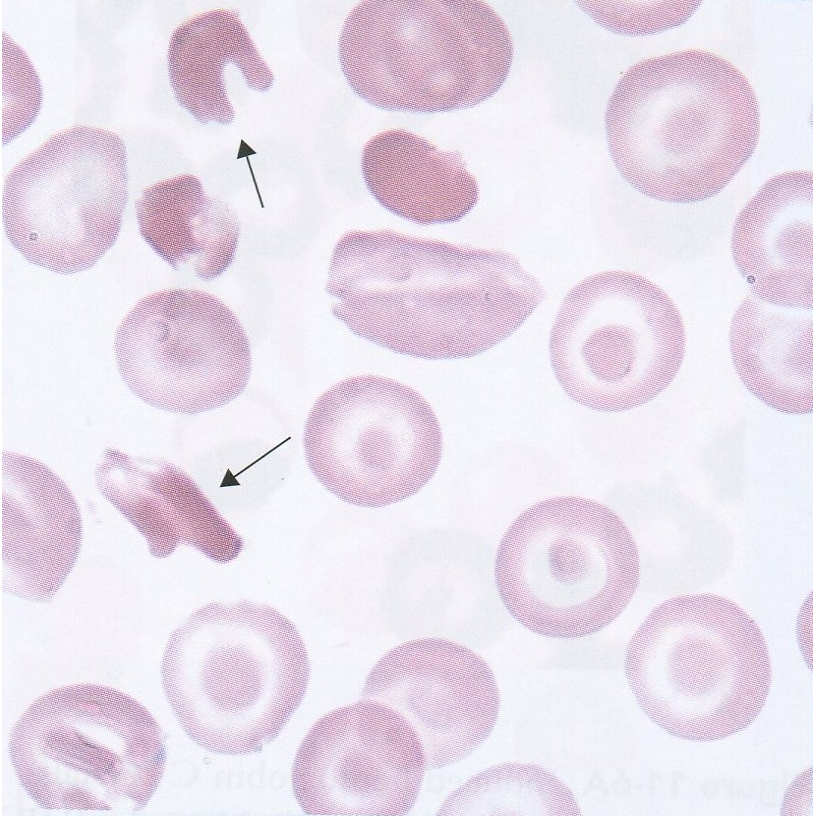

Synthetic Blood Substitutes and Blood Product Market to Reach USD 21.78 Billion by 2030, Driven by Technological Advancements and Rising Demand
The global synthetic blood substitutes and blood product market, valued at USD 7.12 billion in 2023, is projected to grow at a compound annual growth rate (CAGR) of 17.32%, reaching approximately USD 21.78 billion by 2030. This growth is fueled by technological innovations, increasing demand for blood alternatives in medical treatments, and the need for efficient blood management in healthcare systems.
Request Sample Link For More Details: @
https://www.maximizemarketresearch.com/request-sample/137359/
Market Estimation, Growth Drivers, and Opportunities
The market's rapid expansion is attributed to several key factors:
Technological Advancements: Innovations in synthetic blood products, such as Perfluorocarbon-Based Emulsions (PFCs) and Hemoglobin-Based Oxygen Carriers (HBOCs), have enhanced the efficacy and safety of blood substitutes.
Rising Demand in Medical Treatments: The increasing prevalence of chronic diseases, surgical procedures, and trauma cases necessitates reliable blood alternatives, especially in situations where donor blood is scarce or unavailable.
Advantages Over Donor Blood: Synthetic blood substitutes offer benefits like longer shelf life, reduced risk of infections, and universal compatibility, eliminating the need for blood type matching.
Opportunities in the market are further bolstered by ongoing research and development, government initiatives to improve healthcare infrastructure, and the growing adoption of synthetic blood products in emerging economies.
U.S. Market Trends and Investments
In the United States, the synthetic blood substitutes market is witnessing significant advancements:
DARPA's Investment: The Defense Advanced Research Projects Agency (DARPA) has invested in the development of artificial blood products, such as ErythroMer, a synthetic nanoparticle designed to mimic the oxygen-carrying function of red blood cells.
Clinical Trials: Researchers at the University of Maryland School of Medicine are conducting studies on synthetic blood products, aiming to address challenges related to storage, stability, and interaction with the human body.
These initiatives underscore the U.S. commitment to advancing synthetic blood technologies, with potential applications in military medicine, emergency care, and treatment of chronic conditions.
Market Segmentation: Dominant Segments
The market is segmented based on product type, source, application, and end-user:
By Product Type: Hemoglobin-Based Oxygen Carriers (HBOCs) dominate the market, accounting for 45% of the share in 2023, due to their advanced development and efficacy in oxygen transport.
By Source: Synthetic Polymers hold the largest share at 40%, followed by Microorganisms at 35%.
By Application: Cardiovascular diseases represent the largest application segment, comprising 30% of the market, driven by the need for effective blood substitutes in heart-related treatments.
By End-User: Hospitals and clinics are the primary end-users, holding approximately 55% of the market share in 2023, due to their extensive use of blood products in various medical procedures.
About Maximize Market Research:
Maximize Market Research is a multifaceted market research and consulting company with professionals from several industries. Some of the industries we cover include medical devices, pharmaceutical manufacturers, science and engineering, electronic components, industrial equipment, technology and communication, cars and automobiles, chemical products and substances, general merchandise, beverages, personal care, and automated systems. To mention a few, we provide market-verified industry estimations, technical trend analysis, crucial market research, strategic advice, competition analysis, production and demand analysis, and client impact studies.
Contact Maximize Market Research:
3rd Floor, Navale IT Park, Phase 2
Pune Banglore Highway, Narhe,
Pune, Maharashtra 411041, India
sales@maximizemarketresearch.com
+919607365656
Synthetic Blood Substitutes and Blood Product Market to Reach USD 21.78 Billion by 2030, Driven by Technological Advancements and Rising Demand
The global synthetic blood substitutes and blood product market, valued at USD 7.12 billion in 2023, is projected to grow at a compound annual growth rate (CAGR) of 17.32%, reaching approximately USD 21.78 billion by 2030. This growth is fueled by technological innovations, increasing demand for blood alternatives in medical treatments, and the need for efficient blood management in healthcare systems.
Request Sample Link For More Details: @https://www.maximizemarketresearch.com/request-sample/137359/
Market Estimation, Growth Drivers, and Opportunities
The market's rapid expansion is attributed to several key factors:
Technological Advancements: Innovations in synthetic blood products, such as Perfluorocarbon-Based Emulsions (PFCs) and Hemoglobin-Based Oxygen Carriers (HBOCs), have enhanced the efficacy and safety of blood substitutes.
Rising Demand in Medical Treatments: The increasing prevalence of chronic diseases, surgical procedures, and trauma cases necessitates reliable blood alternatives, especially in situations where donor blood is scarce or unavailable.
Advantages Over Donor Blood: Synthetic blood substitutes offer benefits like longer shelf life, reduced risk of infections, and universal compatibility, eliminating the need for blood type matching.
Opportunities in the market are further bolstered by ongoing research and development, government initiatives to improve healthcare infrastructure, and the growing adoption of synthetic blood products in emerging economies.
U.S. Market Trends and Investments
In the United States, the synthetic blood substitutes market is witnessing significant advancements:
DARPA's Investment: The Defense Advanced Research Projects Agency (DARPA) has invested in the development of artificial blood products, such as ErythroMer, a synthetic nanoparticle designed to mimic the oxygen-carrying function of red blood cells.
Clinical Trials: Researchers at the University of Maryland School of Medicine are conducting studies on synthetic blood products, aiming to address challenges related to storage, stability, and interaction with the human body.
These initiatives underscore the U.S. commitment to advancing synthetic blood technologies, with potential applications in military medicine, emergency care, and treatment of chronic conditions.
Market Segmentation: Dominant Segments
The market is segmented based on product type, source, application, and end-user:
By Product Type: Hemoglobin-Based Oxygen Carriers (HBOCs) dominate the market, accounting for 45% of the share in 2023, due to their advanced development and efficacy in oxygen transport.
By Source: Synthetic Polymers hold the largest share at 40%, followed by Microorganisms at 35%.
By Application: Cardiovascular diseases represent the largest application segment, comprising 30% of the market, driven by the need for effective blood substitutes in heart-related treatments.
By End-User: Hospitals and clinics are the primary end-users, holding approximately 55% of the market share in 2023, due to their extensive use of blood products in various medical procedures.
About Maximize Market Research:
Maximize Market Research is a multifaceted market research and consulting company with professionals from several industries. Some of the industries we cover include medical devices, pharmaceutical manufacturers, science and engineering, electronic components, industrial equipment, technology and communication, cars and automobiles, chemical products and substances, general merchandise, beverages, personal care, and automated systems. To mention a few, we provide market-verified industry estimations, technical trend analysis, crucial market research, strategic advice, competition analysis, production and demand analysis, and client impact studies.
Contact Maximize Market Research:
3rd Floor, Navale IT Park, Phase 2
Pune Banglore Highway, Narhe,
Pune, Maharashtra 411041, India
sales@maximizemarketresearch.com
+919607365656